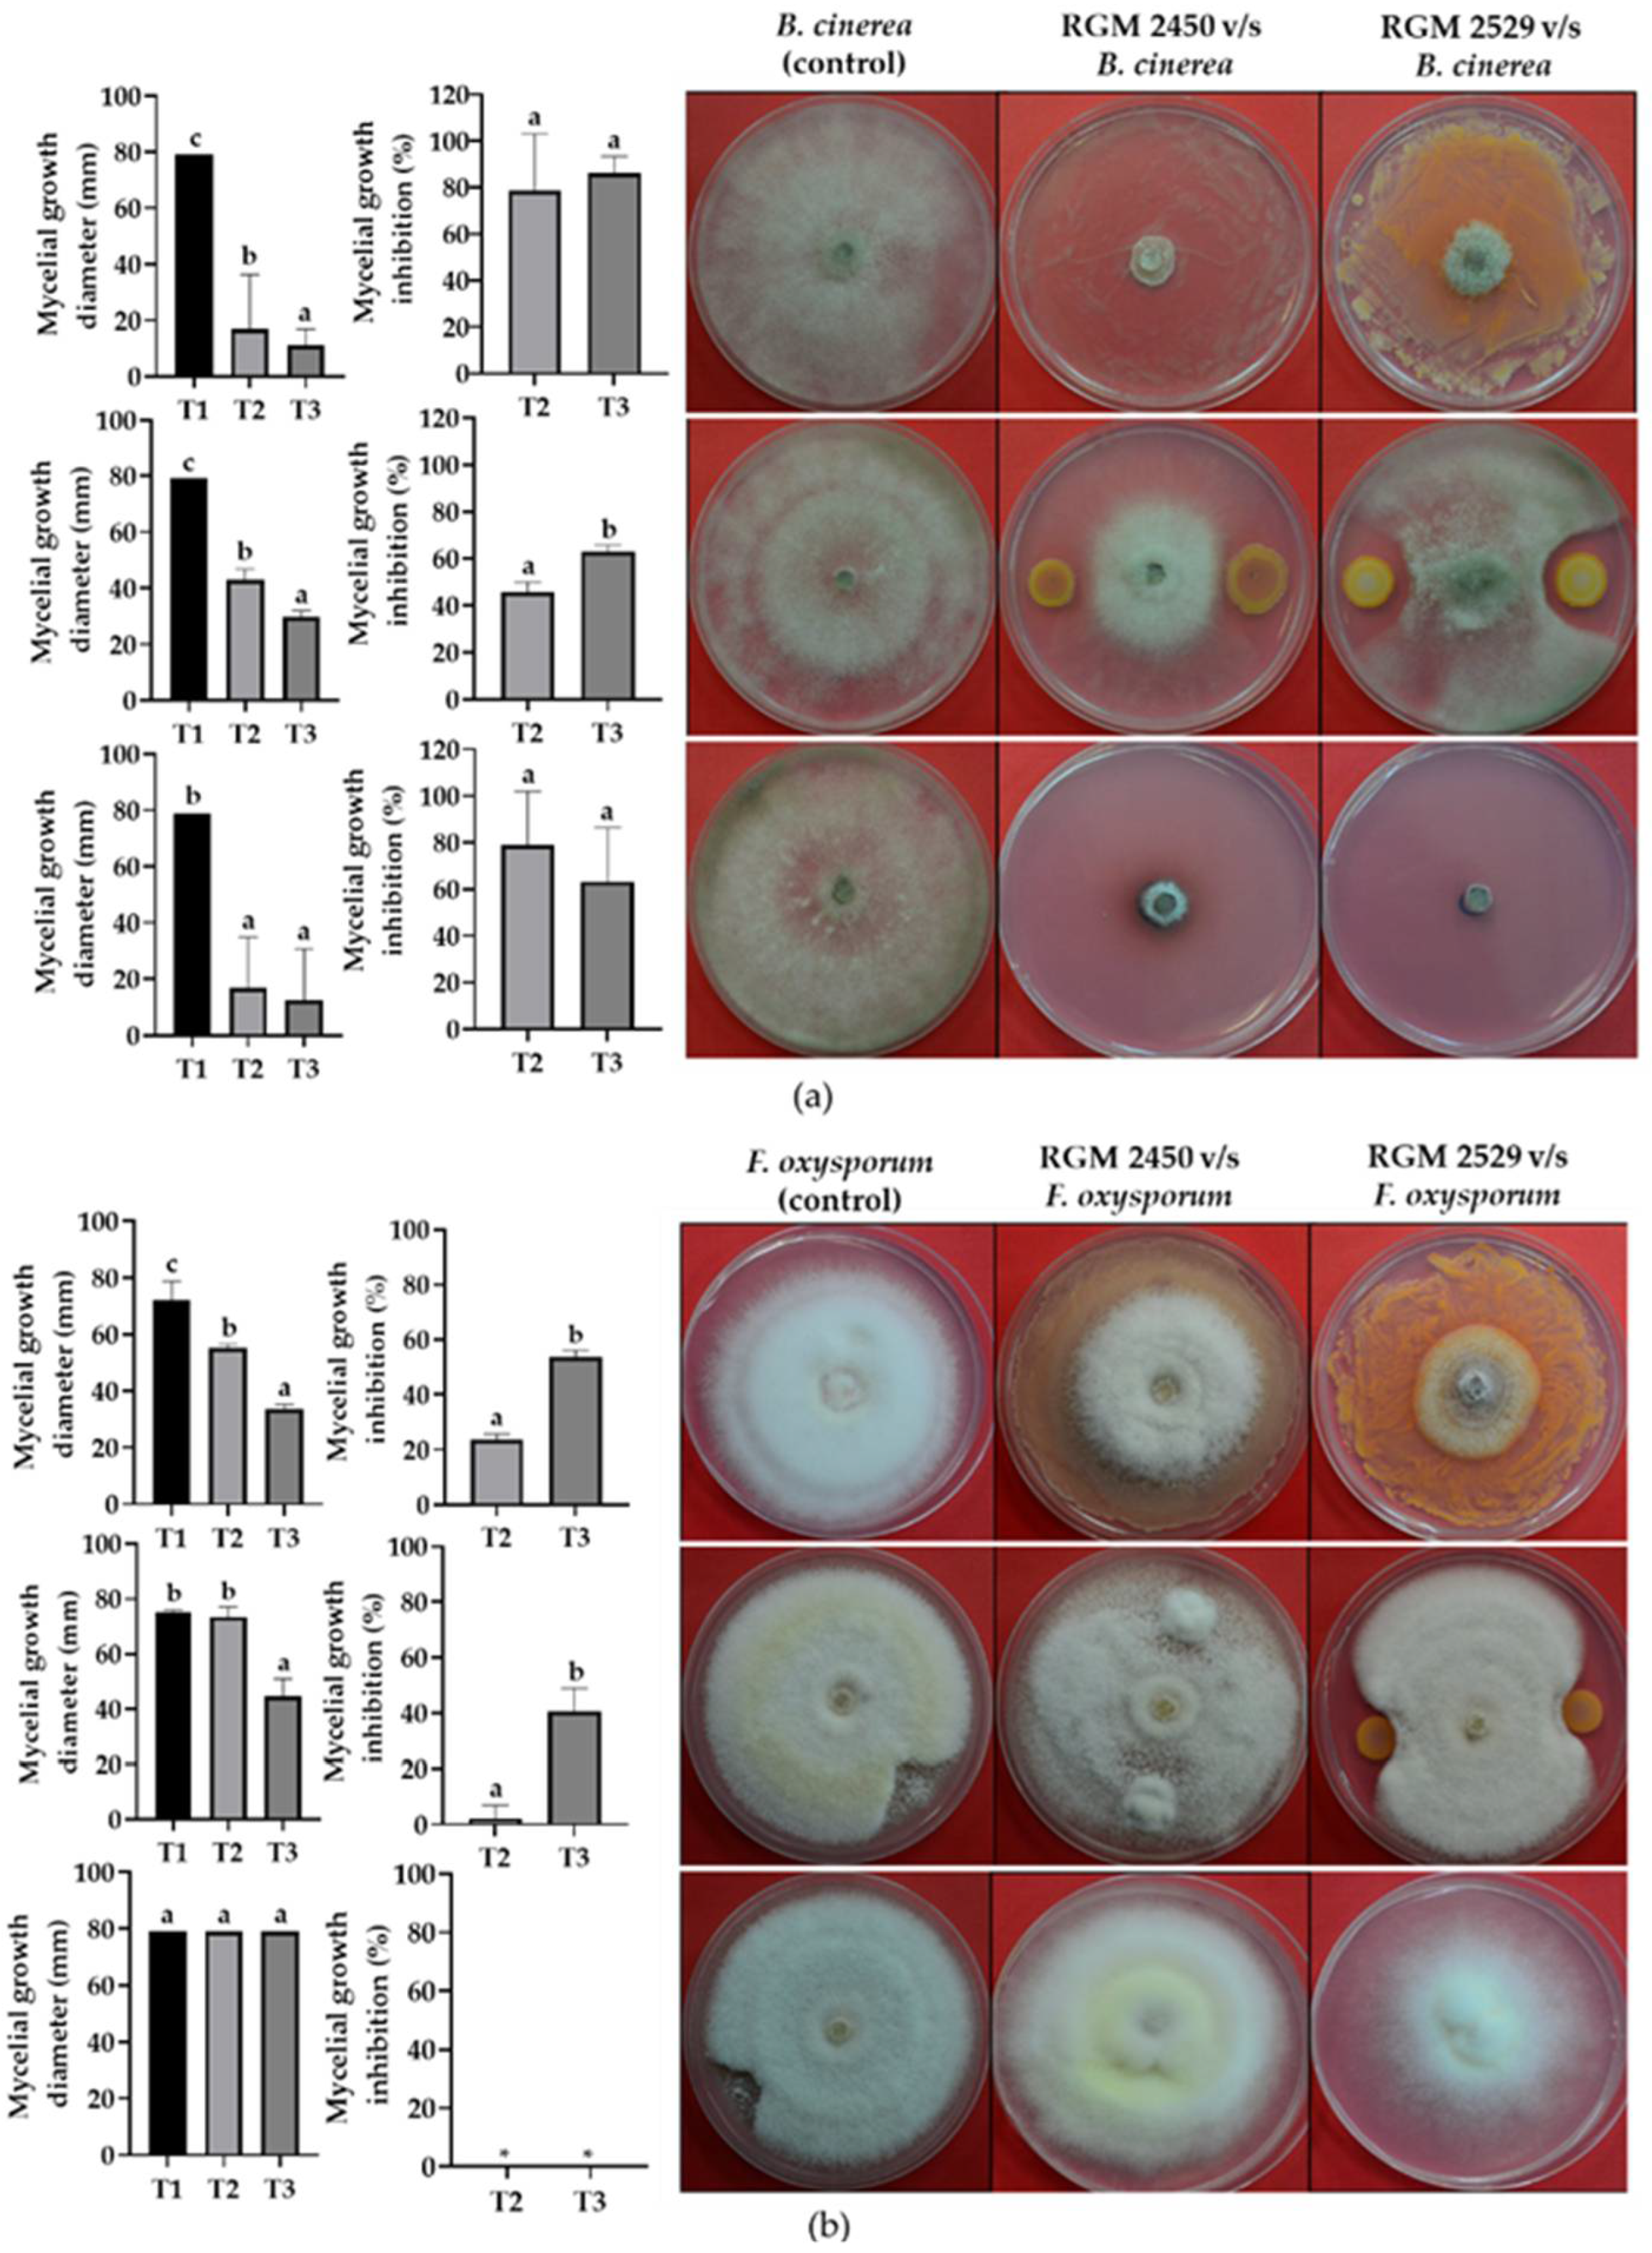
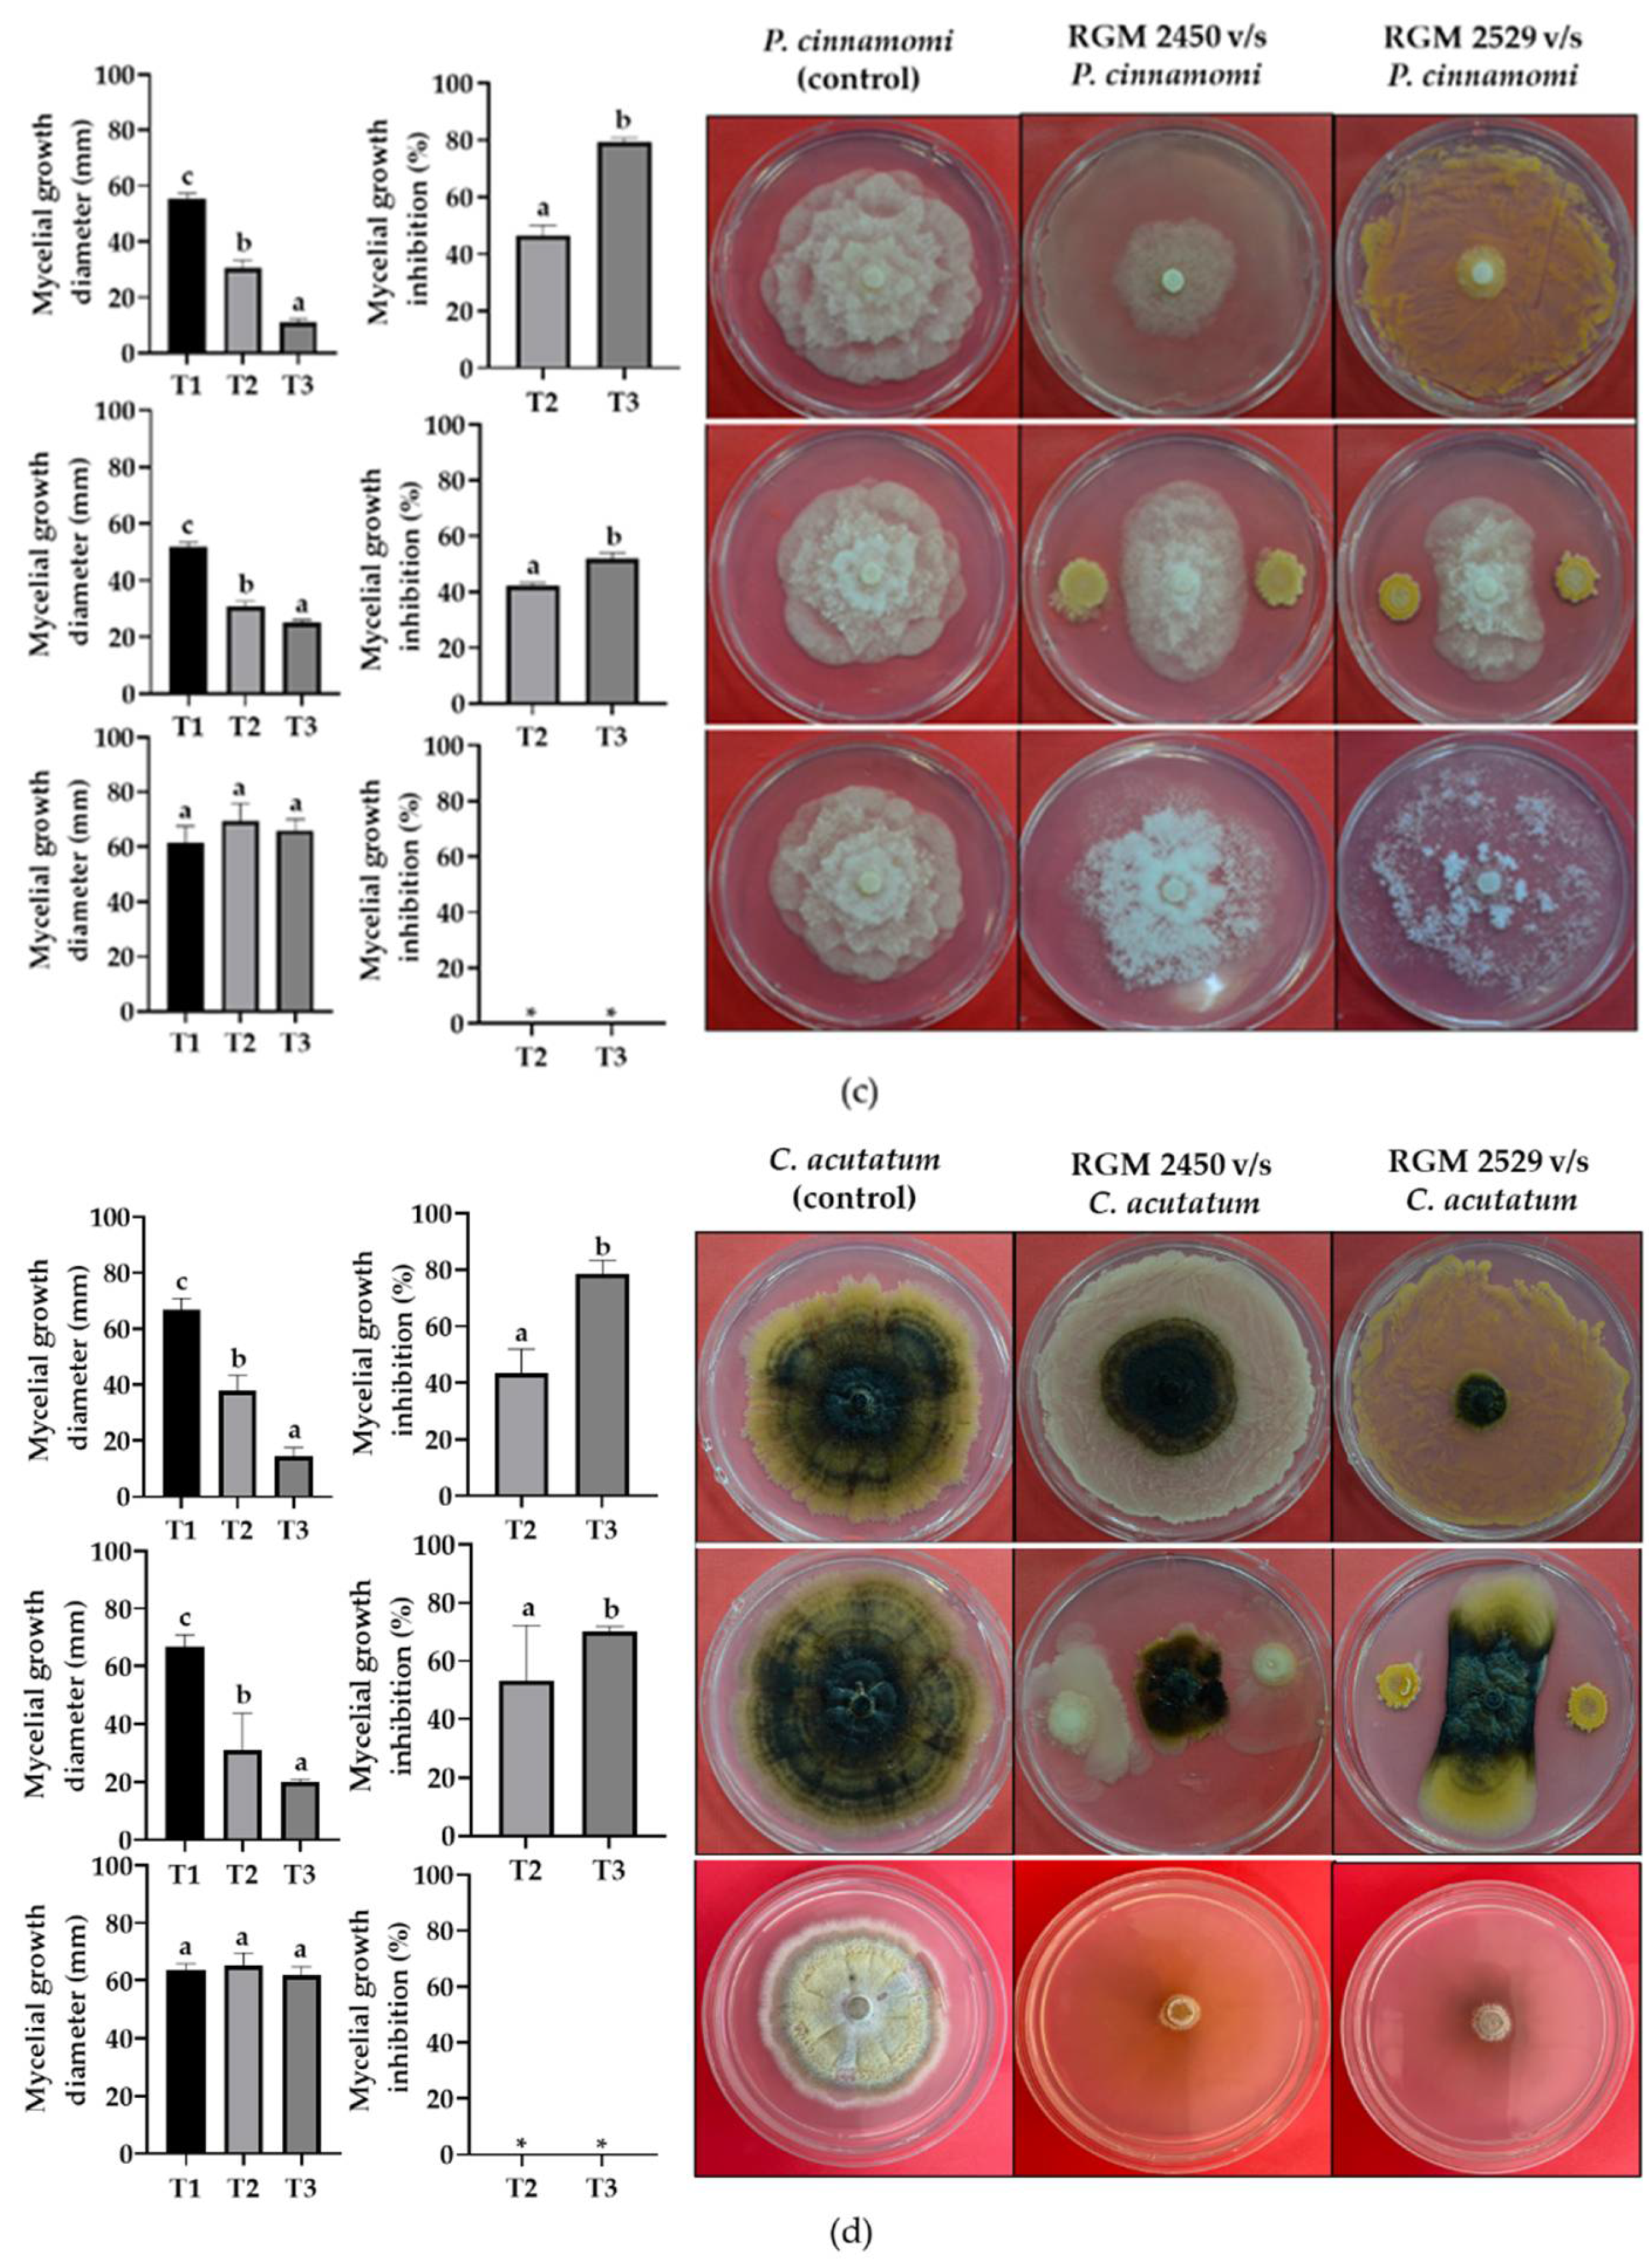

Genomic and Experimental Analysis of the Biostimulant and Antagonistic Properties of Phytopathogens of Bacillus safensis and Bacillus siamensis
Abstract
:1. Introduction
2. Materials and Methods
2.1. Sample Isolation
2.2. Genome Sequencing, Assembly and Annotation
2.3. Identification of the B. safensis RGM 2450 and B. siamensis RGM 2529 Strains
2.4. Comparative Genomic Analysis
2.5. Evaluation of Antagonistic Activity from Competition
2.6. Evaluation of Antagonistic Activity by Diffusible and Volatile Compounds
2.7. Evaluation of Antagonistic Activity of Phytopathogenic Fungus Growth
2.8. Evaluation of Plant-Growth-Promoting Properties
2.9. Evaluation of Tomato Seedling Growth Promotion
2.10. Statistical Analysis
3. Results
3.1. Genome Characteristics and Identification of the B. safensis RGM 2450 and B. siamensis RGM 2529 Strains
3.2. Predicting Secondary Metabolites and Extracellular Enzymes
3.3. Prediction of Pathways Involved in Plant-Growth Promotion
3.4. Evaluation of Strains’ Antagonistic Activity against Phytopathogenic Fungi
3.5. Evaluation of Plant-Growth-Promoting Properties
3.6. Evaluation of PGPR Activity in Tomato Seedlings
4. Discussion
5. Conclusions
Supplementary Materials
Author Contributions
Funding
Institutional Review Board Statement
Informed Consent Statement
Data Availability Statement
Acknowledgments
Conflicts of Interest
References
- Gouda, S.; Kerry, R.G.; Das, G.; Paramithiotis, S.; Shin, H.-S.; Patra, J.K. Revitalization of plant growth promoting rhizobacteria for sustainable development in agriculture. Microbiol. Res. 2018, 206, 131–140. [Google Scholar] [CrossRef] [PubMed]
- De-Bashan, L.E.; Hernandez, J.; Bashan, Y. The potential contribution of plant growth-promoting bacteria to reduce environmental degradation—A comprehensive evaluation. Appl. Soil Ecol. 2012, 61, 171–189. [Google Scholar] [CrossRef]
- Panchami, P.S.; Thanuja, K.G.; Karthikeyan, S. Isolation and Characterization of Indigenous Plant Growth-Promoting Rhizobacteria (PGPR) from Cardamom Rhizosphere. Curr. Microbiol. 2020, 77, 2963–2981. [Google Scholar] [CrossRef] [PubMed]
- Food and Agriculture Organization of the United Nations (FAO). Crops and Livestock Products. Available online: https://www.fao.org/faostat/en/#data/QCL/ (accessed on 4 July 2021).
- Berger, B.; Baldermann, S.; Ruppel, S. The plant growth-promoting bacterium Kosakonia radicincitans improves fruit yield and quality of Solanum lycopersicum. J. Sci. Food Agric. 2017, 97, 4865–4871. [Google Scholar] [CrossRef]
- Hashem, A.; Tabassum, B.; Fathi Abd Allah, E. Bacillus subtilis: A plant-growth promoting rhizobacterium that also impacts biotic stress. Saudi J. Biol. Sci. 2019, 26, 1291–1297. [Google Scholar] [CrossRef]
- Stein, T. Bacillus subtilis antibiotics: Structures, syntheses and specific functions. Mol. Microbiol. 2005, 56, 845–857. [Google Scholar] [CrossRef]
- Fan, B.; Wang, C.; Song, X.; Ding, X.; Wu, L.; Wu, H.; Gao, X.; Borriss, R. Bacillus velezensis FZB42 in 2018: The Gram-Positive Model Strain for Plant Growth Promotion and Biocontrol. Front. Microbiol. 2018, 9, 2491. [Google Scholar] [CrossRef] [Green Version]
- Caulier, S.; Nannan, C.; Gillis, A.; Licciardi, F.; Bragard, C.; Mahillon, J. Overview of the Antimicrobial Compounds Produced by Members of the Bacillus subtilis Group. Front. Microbiol. 2019, 10, 302. [Google Scholar] [CrossRef] [Green Version]
- Sumi, C.D.; Yang, B.W.; Yeo, I.-C.; Hahm, Y.T. Antimicrobial peptides of the genus Bacillus: A new era for antibiotics. Can. J. Microbiol. 2015, 61, 93–103. [Google Scholar] [CrossRef]
- Payne, J.A.E.; Schoppet, M.; Hansen, M.H.; Cryle, M.J. Diversity of nature’s assembly lines—Recent discoveries in non-ribosomal peptide synthesis. Mol. BioSyst. 2016, 13, 9–22. [Google Scholar] [CrossRef]
- Goswami, D.; Thakker, J.N.; Dhandhukia, P.C. Portraying mechanics of plant growth promoting rhizobacteria (PGPR): A review. Cogent Food Agric. 2016, 2, 1127500. [Google Scholar] [CrossRef]
- Bouché, N.; Fromm, H. GABA in plants: Just a metabolite? Trends Plant Sci. 2004, 9, 110–115. [Google Scholar] [CrossRef] [PubMed]
- Nascimento, F.X.; Hernández, A.G.; Glick, B.R.; Rossi, M.J. Plant growth-promoting activities and genomic analysis of the stress-resistant Bacillus megaterium STB1, a bacterium of agricultural and biotechnological interest. Biotechnol. Rep. 2019, 25, e00406. [Google Scholar] [CrossRef]
- Rabbee, M.F.; Ali, M.D.; Choi, J.; Hwang, B.S.; Jeong, S.C.; Baek, K.-H. Bacillus velezensis: A Valuable Member of Bioactive Molecules within Plant Microbiomes. Molecules 2019, 24, 1046. [Google Scholar] [CrossRef] [PubMed] [Green Version]
- Pérez-García, A.; Romero, D.; de Vicente, A. Plant protection and growth stimulation by microorganisms: Biotechnological applications of Bacilli in agriculture. Curr. Opin. Biotechnol. 2011, 22, 187–193. [Google Scholar] [CrossRef]
- Awan, S.A.; Ilyas, N.; Khan, I.; Raza, M.A.; Rehman, A.U.; Rizwan, M.; Rastogi, A.; Tariq, R.; Brestic, M. Bacillus siamensis Reduces Cadmium Accumulation and Improves Growth and Antioxidant Defense System in Two Wheat (Triticum aestivum L.) Varieties. Plants 2020, 9, 878. [Google Scholar] [CrossRef]
- Nazli, F.; Wang, X.; Ahmad, M.; Hussain, A.; Dar, A.; Nasim, M.; Jamil, M.; Panpluem, N.; Mustafa, A. Efficacy of Indole Acetic Acid and Exopolysaccharides-Producing Bacillus safensis Strain FN13 for Inducing Cd-Stress Tolerance and Plant Growth Promotion in Brassica juncea (L.). Appl. Sci. 2021, 11, 4160. [Google Scholar] [CrossRef]
- Islam, A.; Kabir, S.; Khair, A. Characterization and Evaluation of Bacillus siamensis Isolate for its Growth Promoting Potential in Tomato. Agriculture 2019, 65, 42–50. [Google Scholar] [CrossRef]
- Prakash, J.; Arora, N.K. Novel metabolites from Bacillus safensis and their antifungal property against Alternaria alternata. Antonie Van Leeuwenhoek 2021, 114, 1245–1258. [Google Scholar] [CrossRef]
- Pandya, U.; Saraf, M. Purification and characterization of antifungal chitinase from Bacillus safensis MBCU6 and its application for production of chito-oligosaccharides. Biologia 2015, 70, 863–868. [Google Scholar] [CrossRef]
- Rong, S.; Xu, H.; Li, L.; Chen, R.; Gao, X.; Xu, Z. Antifungal activity of endophytic Bacillus safensis B21 and its potential application as a biopesticide to control rice blast. Pestic. Biochem. Physiol. 2019, 162, 69–77. [Google Scholar] [CrossRef]
- Mateus, J.R.; Dal’Rio, I.; Jurelevicius, D.; da Mota, F.F.; Marques, J.M.; Ramos, R.T.J.; Silva, A.L.D.C.D.; Gagliardi, P.R.; Seldin, L. Bacillus velezensis T149-19 and Bacillus safensis T052-76 as Potential Biocontrol Agents against Foot Rot Disease in Sweet Potato. Agriculture 2021, 11, 1046. [Google Scholar] [CrossRef]
- Gorai, P.S.; Ghosh, R.; Mandal, S.; Ghosh, S.; Chatterjee, S.; Gond, S.K.; Mandal, N.C. Bacillus siamensis CNE6- a multifaceted plant growth promoting endophyte of Cicer arietinum L. having broad spectrum antifungal activities and host colonizing potential. Microbiol. Res. 2021, 252, 126859. [Google Scholar] [CrossRef] [PubMed]
- Xu, B.-H.; Lu, Y.-Q.; Ye, Z.-W.; Zheng, Q.-W.; Wei, T.; Lin, J.-F.; Guo, L.-Q. Genomics-guided discovery and structure identification of cyclic lipopeptides from the Bacillus siamensis JFL15. PLoS ONE 2018, 13, e0202893. [Google Scholar] [CrossRef] [PubMed]
- Domingos, D.F.; Faria, A.F.; Galaverna, R.D.S.; Eberlin, M.N.; Greenfield, P.; Zucchi, T.; Melo, I.S.; Tran-Dinh, N.; Midgley, D.; De Oliveira, V.M. Genomic and chemical insights into biosurfactant production by the mangrove-derived strain Bacillus safensis CCMA-560. Appl. Microbiol. Biotechnol. 2015, 99, 3155–3167. [Google Scholar] [CrossRef]
- Pan, H.; Tian, X.; Shao, M.; Xie, Y.; Huang, H.; Hu, J.; Ju, J. Genome mining and metabolic profiling illuminate the chemistry driving diverse biological activities of Bacillus siamensis SCSIO 05746. Appl. Microbiol. Biotechnol. 2019, 103, 4153–4165. [Google Scholar] [CrossRef]
- FastQC. Available online: http://www.bioinformatics.babraham.ac.uk/projects/fastqc/ (accessed on 4 July 2021).
- Bolger, A.M.; Lohse, M.; Usadel, B. Trimmomatic: A flexible trimmer for Illumina sequence data. Bioinformatics 2014, 30, 2114–2120. [Google Scholar] [CrossRef] [Green Version]
- Luo, R.; Liu, B.; Xie, Y.; Li, Z.; Huang, W.; Yuan, J.; He, G.; Chen, Y.; Pan, Q.; Liu, Y.; et al. SOAPdenovo2: An empirically improved memory-efficient short-read de novo assembler. GigaScience 2012, 1, 18. [Google Scholar] [CrossRef]
- Gurevich, A.; Saveliev, V.; Vyahhi, N.; Tesler, G. QUAST: Quality assessment tool for genome assemblies. Bioinformatics 2013, 29, 1072–1075. [Google Scholar] [CrossRef]
- Aziz, R.K.; Bartels, D.; Best, A.A.; DeJongh, M.; Disz, T.; Edwards, R.A.; Formsma, K.; Gerdes, S.; Glass, E.M.; Kubal, M.; et al. The RAST server: Rapid annotations using subsystems technology. BMC Genom. 2008, 9, 75. [Google Scholar] [CrossRef] [Green Version]
- Brettin, T.; Davis, J.J.; Disz, T.; Edwards, R.A.; Gerdes, S.; Olsen, G.J.; Olson, R.; Overbeek, R.; Parrello, B.; Pusch, G.D.; et al. RASTtk: A modular and extensible implementation of the RAST algorithm for building custom annotation pipelines and annotating batches of genomes. Sci. Rep. 2015, 5, 8365. [Google Scholar] [CrossRef] [Green Version]
- Wu, S.; Zhu, Z.; Fu, L.; Niu, B.; Li, W. WebMGA: A customizable web server for fast metagenomic sequence analysis. BMC Genom. 2011, 12, 444. [Google Scholar] [CrossRef] [PubMed] [Green Version]
- Almagro Armenteros, J.J.; Tsirigos, K.D.; Sønderby, C.K.; Petersen, T.N.; Winther, O.; Brunak, S.; Von Heijne, G.; Nielsen, H. SignalP 5.0 improves signal peptide predictions using deep neural networks. Nat. Biotechnol. 2019, 37, 420–423. [Google Scholar] [CrossRef] [PubMed]
- Gardy, J.L.; Laird, M.; Brinkman, F.S.L.; Chen, F.; Rey, S.; Walsh, C.J.; Ester, M. PSORTb v.2.0: Expanded prediction of bacterial protein subcellular localization and insights gained from comparative proteome analysis. Bioinformatics 2004, 21, 617–623. [Google Scholar] [CrossRef] [PubMed] [Green Version]
- AntiSMASH Bacterial Version. Available online: http://antismash.secondarymetabolites.org/ (accessed on 4 July 2021).
- Blin, K.; Shaw, S.; Kloosterman, A.M.; Charlop-Powers, Z.; van Wezel, G.P.; Medema, M.H.; Weber, T. antiSMASH 6.0: Improving cluster detection and comparison capabilities. Nucleic Acids Res. 2021, 49, W29–W35. [Google Scholar] [CrossRef]
- Kumar, S.; Stecher, G.; Tamura, K. MEGA7: Molecular Evolutionary Genetics Analysis Version 7.0 for Bigger Datasets. Mol. Biol. Evol. 2016, 33, 1870–1874. [Google Scholar] [CrossRef] [Green Version]
- Tamura, K. Estimation of the number of nucleotide substitutions when there are strong transition-transversion and G+C-content biases. Mol. Biol. Evol. 1992, 9, 678–687. [Google Scholar] [CrossRef] [Green Version]
- Meier-Kolthoff, J.P.; Auch, A.F.; Klenk, H.-P.; Göker, M. Genome sequence-based species delimitation with confidence intervals and improved distance functions. BMC Bioinform. 2013, 14, 60. [Google Scholar] [CrossRef] [Green Version]
- Sahl, J.W.; Caporaso, J.G.; Rasko, D.A.; Keim, P. The large-scale blast score ratio (LS-BSR) pipeline: A method to rapidly compare genetic content between bacterial genomes. PeerJ 2014, 2, e332. [Google Scholar] [CrossRef] [Green Version]
- Wang, X.; Wang, C.; Li, Q.; Zhang, J.; Ji, C.; Sui, J.; Liu, Z.; Song, X.; Liu, X. Isolation and characterization of antagonistic bacteria with the potential for biocontrol of soil-borne wheat diseases. J. Appl. Microbiol. 2018, 125, 1868–1880. [Google Scholar] [CrossRef]
- Gao, H.; Li, P.; Xu, X.; Zeng, Q.; Guan, W. Research on Volatile Organic Compounds From Bacillus subtilis CF-3: Biocontrol Effects on Fruit Fungal Pathogens and Dynamic Changes During Fermentation. Front. Microbiol. 2018, 9, 456. [Google Scholar] [CrossRef] [PubMed]
- Nautiyal, C.S. An efficient microbiological growth medium for screening phosphate solubilizing microorganisms. FEMS Microbiol. Lett. 1999, 170, 265–270. [Google Scholar] [CrossRef]
- Cherchali, A.; Boukhelata, N.; Kaci, Y.; Abrous-Belbachir, O.; Djebbar, R. Isolation and identification of a phosphate-solubilizing Paenibacillus polymyxa strain GOL 0202 from durum wheat (Triticum durum Desf.) rhizosphere and its effect on some seedlings morphophysiological parameters. Biocatal. Agric. Biotechnol. 2019, 19, 101087. [Google Scholar] [CrossRef]
- Kumari, P.; Meena, M.; Upadhyay, R. Characterization of plant growth promoting rhizobacteria (PGPR) isolated from the rhizosphere of Vigna radiata (mung bean). Biocatal. Agric. Biotechnol. 2018, 16, 155–162. [Google Scholar] [CrossRef]
- Chun, J.; Oren, A.; Ventosa, A.; Christensen, H.; Arahal, D.R.; Da Costa, M.S.; Rooney, A.P.; Yi, H.; Xu, X.-W.; De Meyer, S.; et al. Proposed minimal standards for the use of genome data for the taxonomy of prokaryotes. Int. J. Syst. Evol. Microbiol. 2018, 68, 461–466. [Google Scholar] [CrossRef]
- Strahsburger, E.; Zapata, F.; Pedroso, I.; Fuentes, D.; Tapia, P.; Ponce, R.; McClelland, M.; Valdes, J. Draft Genome Sequence of Bacillus safensis RP10, Isolated from Soil in the Atacama Desert, Chile. Microbiol. Resour. Announc. 2019, 8, e01150-19. [Google Scholar] [CrossRef] [Green Version]
- Laborda, P.R.; Fonseca, F.S.A.; Angolini, C.F.F.; Oliveira, V.M.; Souza, A.P.; Marsaioli, A.J. Genome Sequence of Bacillus safensis CFA06, Isolated from Biodegraded Petroleum in Brazil. Genome Announc. 2014, 2, e00642-14. [Google Scholar] [CrossRef] [Green Version]
- Jeong, H.; Jeong, D.-E.; Kim, S.H.; Song, G.C.; Park, S.-Y.; Ryu, C.-M.; Park, S.-H.; Choi, S.-K. Draft Genome Sequence of the Plant Growth-Promoting Bacterium Bacillus siamensis KCTC 13613 T. J. Bacteriol. 2012, 194, 4148–4149. [Google Scholar] [CrossRef] [Green Version]
- Kalyon, B.; Helaly, S.E.; Scholz, R.; Nachtigall, J.; Vater, J.; Borriss, R.; Süssmuth, R.D. Plantazolicin A and B: Structure Elucidation of Ribosomally Synthesized Thiazole/Oxazole Peptides from Bacillus amyloliquefaciens FZB42. Org. Lett. 2011, 13, 2996–2999. [Google Scholar] [CrossRef]
- Molohon, K.J.; Saint-Vincent, P.M.B.; Park, S.; Doroghazi, J.R.; Maxson, T.; Hershfield, J.R.; Flatt, K.M.; Schroeder, N.E.; Ha, T.; Mitchell, D.A. Plantazolicin Is an Ultranarrow-Spectrum Antibiotic That Targets the Bacillus anthracis Membrane. ACS Infect. Dis. 2015, 2, 207–220. [Google Scholar] [CrossRef] [Green Version]
- Yu, X.; Ai, C.; Xin, L.; Zhou, G. The siderophore-producing bacterium, Bacillus subtilis CAS15, has a biocontrol effect on Fusarium wilt and promotes the growth of pepper. Eur. J. Soil Biol. 2011, 47, 138–145. [Google Scholar] [CrossRef]
- Zhou, M.; Liu, F.; Yang, X.; Jin, J.; Dong, X.; Zeng, K.-W.; Liu, D.; Zhang, Y.; Ma, M.; Yang, D. Bacillibactin and Bacillomycin Analogues with Cytotoxicities against Human Cancer Cell Lines from Marine Bacillus sp. PKU-MA00093 and PKU-MA00092. Mar. Drugs 2018, 16, 22. [Google Scholar] [CrossRef] [PubMed] [Green Version]
- Steinborn, G.; Hajirezaei, M.-R. bac genes for recombinant bacilysin and anticapsin production in Bacillus host strains. Arch. Microbiol. 2004, 183, 71–79. [Google Scholar] [CrossRef] [PubMed]
- Caulier, S.; Gillis, A.; Colau, G.; Licciardi, F.; Liépin, M.; Desoignies, N.; Modrie, P.; Legrève, A.; Mahillon, J.; Bragard, C. Versatile Antagonistic Activities of Soil-Borne Bacillus spp. and Pseudomonas spp. against Phytophthora infestans and Other Potato Pathogens. Front. Microbiol. 2018, 9, 143. [Google Scholar] [CrossRef]
- Anuradha, S.N. Structural and molecular characteristics of lichenysin and its relationship with surface activity. Adv. Exp. Med. Biol. 2010, 672, 304–315. [Google Scholar] [CrossRef]
- Grangemard, I.; Wallach, J.; Maget-Dana, R.; Peypoux, F. Lichenysin: A More Efficient Cation Chelator Than Surfactin. Appl. Biochem. Biotechnol. 2001, 90, 199–210. [Google Scholar] [CrossRef]
- Scholz, R.; Vater, J.; Budiharjo, A.; Wang, Z.; He, Y.; Dietel, K.; Schwecke, T.; Herfort, S.; Lasch, P.; Borriss, R. Amylocyclicin, a Novel Circular Bacteriocin Produced by Bacillus amyloliquefaciens FZB42. J. Bacteriol. 2014, 196, 1842–1852. [Google Scholar] [CrossRef] [Green Version]
- Perumal, V.; Yao, Z.; A Kim, J.; Kim, H.-J. Purification and Characterization of a Bacteriocin, BacBS2, Produced by Bacillus velezensis BS2 Isolated from Meongge Jeotgal. J. Microbiol. Biotechnol. 2019, 29, 1033–1042. [Google Scholar] [CrossRef]
- Peypoux, F.; Bonmatin, J.M.; Wallach, J. Recent trends in the biochemistry of surfactin. Appl. Microbiol. Biotechnol. 1999, 51, 553–563. [Google Scholar] [CrossRef]
- Bais, H.P.; Fall, R.; Vivanco, J.M. Biocontrol of Bacillus subtilis against Infection of Arabidopsis Roots by Pseudomonas syringae Is Facilitated by Biofilm Formation and Surfactin Production. Plant Physiol. 2004, 134, 307–319. [Google Scholar] [CrossRef] [Green Version]
- Cawoy, H.; Debois, D.; Franzil, L.; De Pauw, E.; Thonart, P.; Ongena, M. Lipopeptides as main ingredients for inhibition of fungal phytopathogens byBacillus subtilis/amyloliquefaciens. Microb. Biotechnol. 2014, 8, 281–295. [Google Scholar] [CrossRef] [PubMed]
- Preecha, C.; Sadowsky, M.J.; Prathuangwong, S. Lipopeptide surfactin produced by Bacillus amyloliquefaciens KPS46 is required for biocontrol efficacy against Xanthomonas axonopodis pv. glycines. J. Nat. Sci. 2010, 44, 84–99. [Google Scholar]
- Romano, A.; Vitullo, D.; Senatore, M.; Lima, G.; Lanzotti, V. Antifungal Cyclic Lipopeptides from Bacillus amyloliquefaciens Strain BO5A. J. Nat. Prod. 2013, 76, 2019–2025. [Google Scholar] [CrossRef]
- Sabaté, D.C.; Audisio, M.C. Inhibitory activity of surfactin, produced by different Bacillus subtilis subsp. subtilis strains, against Listeria monocytogenes sensitive and bacteriocin-resistant strains. Microbiol. Res. 2013, 168, 125–129. [Google Scholar] [CrossRef] [PubMed]
- Kwon, J.W.; Kim, S.D. Characterization of an Antibiotic Produced by Bacillus subtilis JW-1 that Suppresses Ralstonia solanacearum. J. Microbiol. Biotechnol. 2014, 24, 13–18. [Google Scholar] [CrossRef] [Green Version]
- Loiseau, C.; Schlusselhuber, M.; Bigot, R.; Bertaux, J.; Berjeaud, J.-M.; Verdon, J. Surfactin from Bacillus subtilis displays an unexpected anti-Legionella activity. Appl. Microbiol. Biotechnol. 2015, 99, 5083–5093. [Google Scholar] [CrossRef]
- Koumoutsi, A.; Chen, X.-H.; Henne, A.; Liesegang, H.; Hitzeroth, G.; Franke, P.; Vater, J.; Borriss, R. Structural and Functional Characterization of Gene Clusters Directing Nonribosomal Synthesis of Bioactive Cyclic Lipopeptides in Bacillus amyloliquefaciens Strain FZB42. J. Bacteriol. 2004, 186, 1084–1096. [Google Scholar] [CrossRef] [Green Version]
- Yang, J.; Zhu, X.; Cao, M.; Wang, C.; Zhang, C.; Lu, Z.; Lu, F. Genomics-Inspired Discovery of Three Antibacterial Active Metabolites, Aurantinins B, C, and D from Compost-Associated Bacillus subtilis fmb60. J. Agric. Food Chem. 2016, 64, 8811–8820. [Google Scholar] [CrossRef]
- Dogan, G.; Taskin, B. Hydrolytic Enzymes Producing Bacterial Endophytes of Some Poaceae Plants. Pol. J. Microbiol. 2021, 70, 297–304. [Google Scholar] [CrossRef]
- Dean, R.; Van Kan, J.A.L.; Pretorius, Z.A.; Hammond-Kosack, K.E.; Di Pietro, A.; Spanu, P.D.; Rudd, J.J.; Dickman, M.; Kahmann, R.; Ellis, J.; et al. The Top 10 fungal pathogens in molecular plant pathology. Mol. Plant Pathol. 2012, 13, 414–430. [Google Scholar] [CrossRef] [Green Version]
- Wakeham, A.; Langton, A.; Adams, S.; Kennedy, R. Interface of the environment and occurrence of Botrytis cinerea in pre-symptomatic tomato crops. Crop Prot. 2016, 90, 27–33. [Google Scholar] [CrossRef]
- Husaini, A.M.; Sakina, A.; Cambay, S.R. Host–Pathogen Interaction in Fusarium oxysporum Infections: Where Do We Stand? Mol. Plant-Microbe Interact. 2018, 31, 889–898. [Google Scholar] [CrossRef] [PubMed] [Green Version]
- Boyd, E.S.; Anbar, A.D.; Miller, S.; Hamilton, T.L.; Lavin, M.; Peters, J.W. A late methanogen origin for molybdenum-dependent nitrogenase. Geobiology 2011, 9, 221–232. [Google Scholar] [CrossRef] [PubMed]
- Oshkin, I.Y.; Miroshnikov, K.K.; Danilova, O.V.; Hakobyan, A.; Liesack, W.; Dedysh, S.N. Thriving in Wetlands: Ecophysiology of the Spiral-Shaped Methanotroph Methylospira mobilis as Revealed by the Complete Genome Sequence. Microorganisms 2019, 7, 683. [Google Scholar] [CrossRef] [PubMed] [Green Version]

Publisher’s Note: MDPI stays neutral with regard to jurisdictional claims in published maps and institutional affiliations. |
© 2022 by the authors. Licensee MDPI, Basel, Switzerland. This article is an open access article distributed under the terms and conditions of the Creative Commons Attribution (CC BY) license (https://creativecommons.org/licenses/by/4.0/).
Share and Cite
Altimira, F.; Godoy, S.; Arias-Aravena, M.; Araya, B.; Montes, C.; Castro, J.F.; Dardón, E.; Montenegro, E.; Pineda, W.; Viteri, I.; et al. Genomic and Experimental Analysis of the Biostimulant and Antagonistic Properties of Phytopathogens of Bacillus safensis and Bacillus siamensis. Microorganisms 2022, 10, 670. https://doi.org/10.3390/microorganisms10040670
Altimira F, Godoy S, Arias-Aravena M, Araya B, Montes C, Castro JF, Dardón E, Montenegro E, Pineda W, Viteri I, et al. Genomic and Experimental Analysis of the Biostimulant and Antagonistic Properties of Phytopathogens of Bacillus safensis and Bacillus siamensis. Microorganisms. 2022; 10(4):670. https://doi.org/10.3390/microorganisms10040670
Chicago/Turabian StyleAltimira, Fabiola, Sebastián Godoy, Matias Arias-Aravena, Bárbara Araya, Christian Montes, Jean Franco Castro, Elena Dardón, Edgar Montenegro, Wilson Pineda, Ignacio Viteri, and et al. 2022. "Genomic and Experimental Analysis of the Biostimulant and Antagonistic Properties of Phytopathogens of Bacillus safensis and Bacillus siamensis" Microorganisms 10, no. 4: 670. https://doi.org/10.3390/microorganisms10040670
APA StyleAltimira, F., Godoy, S., Arias-Aravena, M., Araya, B., Montes, C., Castro, J. F., Dardón, E., Montenegro, E., Pineda, W., Viteri, I., & Tapia, E. (2022). Genomic and Experimental Analysis of the Biostimulant and Antagonistic Properties of Phytopathogens of Bacillus safensis and Bacillus siamensis. Microorganisms, 10(4), 670. https://doi.org/10.3390/microorganisms10040670

